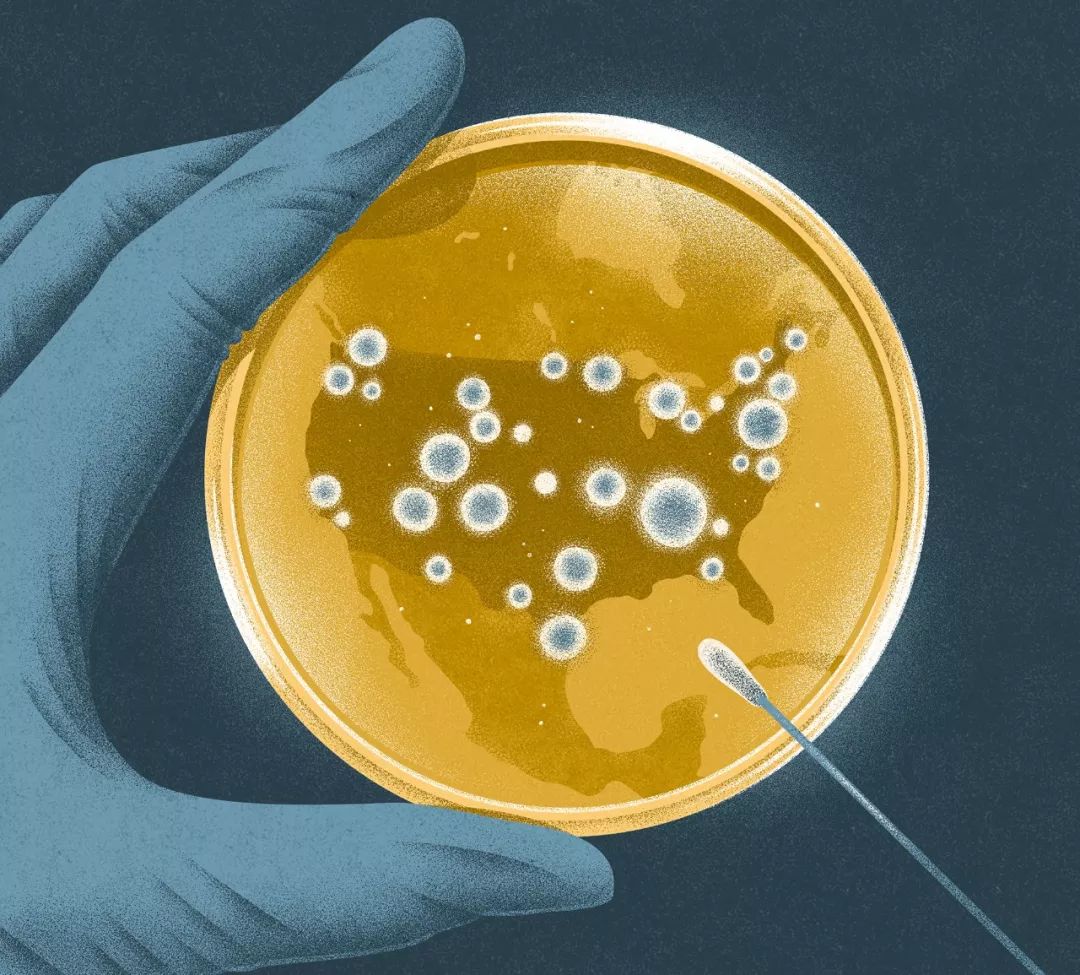
1561174724957580.jpeg

插画设计创意欣赏,2019世界插画奖获奖作品公布

世界插画奖是对全球插画家开放的最负盛名的年度评审比赛,该奖项由插画师协会(The Association of Illustrators,The AOI)与插画目录(Directory of Illuatration)共同举办。
获奖作品全览
▼
书籍类
Book
类别大奖
Category Winner
广场之眼
Square Eyes
作者:Anna Mill





一本插画合辑
Illustre Bilder – an illustration collection
作者:Sua Balac




好评作品
Highly Commended
《玛丽·安东尼》
Marie Antoinette
作者:Jen Yoon(Jeongin Yoon)





《霍克斯岛》
Hoakes Island
作者:Helen Friel





儿童读物类
Children's Books
类别大奖
Category Winner
《看》
Look
作者:Fiona Woodcock





我的狒狒藏在哪里?
Where is My Baboon Hiding?
作者:Dani Choi





好评作品
Highly Commended
雅诺·萨里宁的一生
The Baron - Life of Jarno Saarinen
作者:Pirita Tolvanen





管弦乐队
Orchestra
作者:Yeon Gyong Joo





广告类
Advertising
类别大奖
Category Winner
RAU —— 以自然为基础的烹饪
RAU - nature based cuisine
作者:Sonja Stangl





社区艺术海报
Community Art Poster:
Arts in the Three Lamps District
作者:Yang Sio Maan

好评作品
Highly Commended
夜晚在......
In Night at/in ...
作者:VIrginie Kypriotis



广告狂人Instagram广告项目
Mad Men Instagram advertising project
作者:Damien Jeon(Seo young Jeon)





设计类
Design
类别大奖
Category Winner
改良人
Modified Man
作者:Tim Easley





故事线索:一个插图观光工具包
Tale Trail: An Illustrated Sightseeing Kit
作者:Fruzsina Fölföldi





好评作品
Highly Commended
Stiegl
作者:MaïtéFranchi





明信片
Me-Time-Postcards
作者:Marc Lehmann





编辑社论类
Editorial
类别大奖
Category Winner
ADD in Women
作者:Lin Chen




何时停止
When to stop
作者:Eleni Debo




好评作品
Highly Commended
回嘴
Back Talk
作者:Amber Vittoria

亚热带大都市
Semitropical Metropolis
作者:Ginko Yang



实验性作品
Experimental
类别大奖
Category Winner
失真
Distortion
作者:Magoz

连接
Connectivity
作者:Patrick Dias



好评作品
Highly Commended
第二选集
An Anthology vol.2
作者:Yukai Du





时间机器
The Time Machine
作者:Anne Roos Kleiss



研究型插画
Research
类别大奖
Category Winner
伊莎多拉·邓肯
Isadora Duncan
作者:Kathryn Martin

在风景中
In a landscape
作者:muto





好评作品
Highly Commended
传染病
The Lancet Infectious Diseases
作者:Kouzou Sakai

如何造就一个悲观主义者......或不
How to make a pessimist...or not.
作者:Isa Loureiro

特定场域
Site Specific
类别大奖
Category Winner
纽约街道
NYC Streets
作者:Jinhwa Jang





如果墙可以说话
If These Walls Could Talk
作者:Astrid Jaekel




好评作品
Highly Commended
圣诞色彩
Christmas in Colour
作者:Thomas Hedger




比金山纪念博物馆——夜莺咖啡馆的壁画
Biggin Hill Memorial Museum
The Nightingale Café’s Mural
作者:Olivia Boutrou



来源:Hiiibrand(ID:hiiibrand_com)
注:版权归原作者所有,在此仅供交流学习
猜你喜欢
![]()